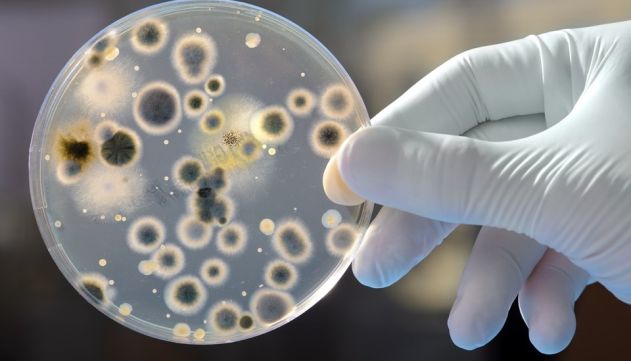

A maioria das pessoas só começa a se preocupar com a saúde quando surge um problema médico, correndo para buscar remédios e tratamentos que possam resolvê-lo.
Os pacientes geralmente nos procuram pela dor, e não exatamente pelo amor à saúde! E quando falo de dor não estou falando de dor literal em costas, joelhos, etc. Como assim? A tendência do ser humano é buscar ajuda quando a dor já está no limite, isso é, quando o médico já mandou mudar seu estilo de vida ou quando a dor, ou tensão muscular, já se tornou crônica. E raramente, muito raramente as pessoas pensam em prevenir sem que esses problemas necessariamente surjam.
O maior problema nesse tipo de mentalidade é que pensamos em cuidar da saúde quando um problema surge. Então, na realidade quando falamos em cuidar de saúde, estamos na verdade falando em tratar de uma doença já instaurada. Mas, e se pudéssemos repensar que não é preciso ter uma doença para começarmos a nos cuidar de verdade?
Voltamos à vida real do nosso contexto de fisioterapia, pilates e exercícios de fortalecimento preventivos com fisioterapeuta, sabemos na prática que iniciar qualquer tratamento demanda! Reavaliar o estilo de vida e mudanças de forma geral, são difíceis para qualquer pessoa. Para quem começa a se cuidar, é preciso mudar a rotina, muitas vezes, organizar o financeiro e investir o mais importante e escasso que possuímos, o tempo!
Veja também
Superbactéria que representa risco de saúde global é detectada no Nordeste
Hemobrás faz auditoria para qualificação do plasma produzido pelo Hemoam
.jpeg)
Mas mais do que a ideação e a decisão em começar algo, é preciso se atentar que a adesão ao tratamento/ às mudanças é que farão a diferença de verdade! Isso é, não adianta pagar o tratamento caríssimo ou o pilates, se você falta ou se você simplesmente não segue as orientações clínicas.
O real problema
Mas e se você está aderente ao tratamento e mesmo assim não evolui? Vale justamente relembrar do mais básico do básico: a ciência já comprovou que estresse crônico e todo contexto não fisiológico que vivemos, influencia de forma direta a forma que nosso corpo funciona!Não adianta esperar de um corpo que sempre foi exposto a condições super estressoras, funcione e trabalhe da mesma forma que o paciente ao lado que está no mesmo tratamento, mas que cuida da saúde de forma global e é super consistente nos hábitos saudáveis da alimentação ao sono reparador.Vamos pensar juntos…
Intuitivamente, você acha que uma pessoa que tem uma bagagem e contexto X e outra, com contexto absolutamente oposto, responderão a um mesmo estímulo Z de tratamento ou exercícios de forma igual ou diferente?Por exemplo, gosto de trazer essa visualização porque é muito fácil de imaginarmos: os atletas de fim de semana geralmente são pessoas que na rotina real (de segunda a sexta-feira) tem comportamento sedentário, não realizam nenhuma exercício de fortalecimento ou mobilidade, fumam, se alimentam mal, não se hidratam, dormem pouco e tem o estresse nas alturas, e que apenas jogam partidas de beach tênis, futebol, etc no domingo.
Ao jogar essa partida —a curto e longo prazo, o corpo responderá ao jogo —considerado uma atividade naturalmente estressora aguda para o organismo —de forma diferente de uma pessoa com comportamento e estilo de vida oposto: uma pessoa que treina de segunda a sexta-feira, possui uma alimentação equilibrada e com controle de sono de 8-9h ininterruptas com todo o suporte e manejo de estresse. Possivelmente, caso uma lesão ocorra, especialmente as crônicas, a “culpa” não será exatamente daquele “beachzinho” ou futebolzinho de final de semana, mas sim da resposta a todo contexto e condições escolhidas ao corpo com aquele determinado estímulo de estresse físico pontual.
As consequências. Não é à toa, dispomos cada vez mais de estratégias de recuperação física —seja nas áreas de nutrição, no uso de tecnologias da própria fisioterapia como o recovery muscular que busca ajudar o corpo a se recuperar, e até nas estratégias de produtos que prometem ser antioxidantes. Atenção, aqui vale dizer que nenhum alimento, equipamento ou medicamento por si só não rsolve o problema: é preciso sempre entender a saúde como uma construção de um trabalho integrado de alimentação, exercícios, sono, etc.
(466).jpeg)
“Mas e na fisioterapia, como estimular o processo de reparo de músculos, articulações, osso para uma reabilitação completa?” —essa é a pergunta de milhões.Sempre ouço aqui e acolá que a fisioterapia não funciona, e fico pasma. Alguns dirão que é o ego profissional, mas acho que incomoda a feridinha de que há excelentes profissionais de saúde dando tudo por seus pacientes e que, ainda assim, podem não ter a expectativa de melhora atendida!
Mas aqui me vem também muito mais, o incômodo desse lugar de sabermos que na saúde não controlamos TODA saúde do paciente. Não dependemos apenas do nosso skill, mas também da adesão do paciente para o sucesso do tratamento, que é influenciado por todo contexto anteriormente citado de alimentação, sono, recuperação e de contexto emocional.
De forma prática, o que posso fazer agora para ajudar meu corpo na minha recuperação?
(377).jpeg)
Fotos: Reprodução/Google
Durma bem e recupere. Um processo natural de recuperação do metabolismo é o descanso! Insira a higiene do sono na sua vida e perceba como você estará proporcionando um contexto de saúde melhor para sua recuperação.
Manejo de estresse crônico. Ansiedade, depressão, burnout… nosso estilo de vida associado ao excesso de cortisol de forma crônica gera resposta exacerbada inflamatória com o corpo em alerta e, com isso, a prioridade não será em recuperar seu corpo. Por isso, reveja se meditação e técnicas respiratórias podem ajudar! Busque ajuda de um psicólogo, pois eles são os profissionais que podem trazer todo suporte e avaliação clínica necessária para te dar ferramentas de controle.
Hidratação. Beba água mais reponha energia —frutas + oleaginosas + construa músculos —priorize fonte de proteínas animais e vegetais. Dê preferência a alimentos antioxidantes e antiinflamatórios (açafrão-da-terra, aveia, azeite de oliva, frutas cítricas, frutas vermelhas, linhaça, mamão/abacaxi, melão, óleo de gergelim, peixes —salmão/atum/sardinha/arenque, pepino, sálvia, semente de abóbora, suco de uva integral, gengibre, tomate orgânico, alho, pimenta, maracujá, romã, chá verde e chia) e evite alimentos muito gordurosos ou com muita fritura, assim como, alimentos ultraprocessados. Se você tem dúvidas sobre alimentação, não hesite em buscar orientação de um nutricionista.
Lembre-se que a estratégia nutricional, fisioterapêutica ou psicológica para manejo de estresse crônico deve ser individualizada, o objetivo de hoje é que você se conscientize de que sua saúde depende do cuidado integrado em todos os aspectos do seu estilo de vida. Todas as escolhas e decisões irão influenciar de forma direta a forma que seu corpo se recupera e funciona. Procure sempre por profissionais de saúde para atendimento adequado.
Fonte: com informações Revista IstoÉ
Copyright © 2021-2026. Mulher Amazônica - Todos os direitos reservados.